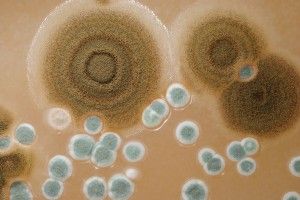

Install a Dehumidifier This Spring
High Humidity Makes for Problems As human beings, we’re most comfortable when the relative humidity (which measures the amount of ambient moisture in the air) sits somewhere between 20% and 50%. If it gets any higher, there’s too...
Read more